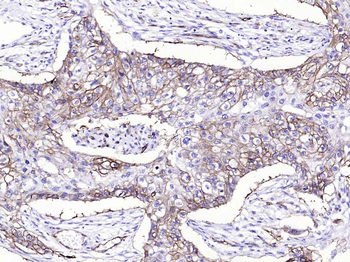
Integrin alpha 2 Recombinant Rabbit Monoclonal Antibody

You have no items in your shopping cart.
- Collagen Type I Antibody [orb345343]
DOT, ELISA, FLISA, IHC, IP, WB
Bovine, Human, Mouse, Porcine, Rat
Rabbit
Polyclonal
Unconjugated
100 μg - Collagen Type I Antibody [orb345344]
DOT, ELISA, FLISA, IHC, IP, WB
Bovine, Human, Mouse, Porcine, Rat
Rabbit
Polyclonal
Unconjugated
500 μg - Collagen Type I Antibody [orb345345]
DOT, ELISA, FLISA, IHC, IP, WB
Bovine, Human, Mouse, Porcine, Rat
Rabbit
Polyclonal
Unconjugated
25 μl - COL2A1 antibody [orb10436]Featured

ELISA, ICC, IF, IHC-P, WB
Human, Mouse, Rat
Rabbit
Polyclonal
Unconjugated
100 μg - Featured

IF, IHC-Fr, IHC-P, WB
Human, Mouse, Rat
Mouse, Rat
Rabbit
Recombinant
Unconjugated
100 μl, 50 μl, 25 μl - Collagen 4 alpha 1 antibody [orb382133]Featured

ICC, IF, IHC-P, WB
Human, Mouse, Rat
Rabbit
Polyclonal
Unconjugated
100 μg - Collagen Type IV Antibody [orb345353]
DOT, ELISA, IHC, IP, WB
Bovine, Human
Rabbit
Polyclonal
Unconjugated
500 μg - Collagen Type IV Antibody [orb345352]
DOT, ELISA, IHC, IP, WB
Bovine, Human
Rabbit
Polyclonal
Unconjugated
100 μg - Featured

ICC, IF, IHC-Fr, IHC-P, WB
Human, Mouse, Rat
Mouse, Rat
Rabbit
Recombinant
Unconjugated
25 μl, 50 μl, 100 μl